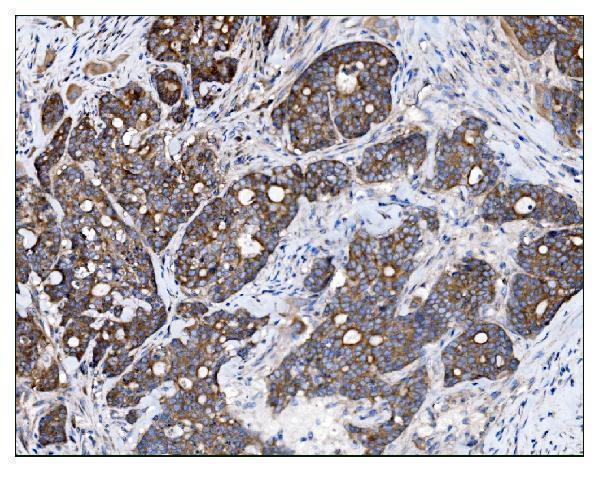
a02004 3 tbc1d4 primary antibodies ihc testing 2
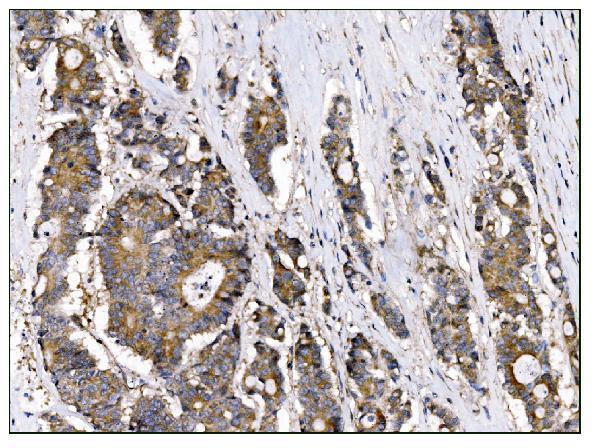
a02004 3 tbc1d4 primary antibodies ihc testing 3
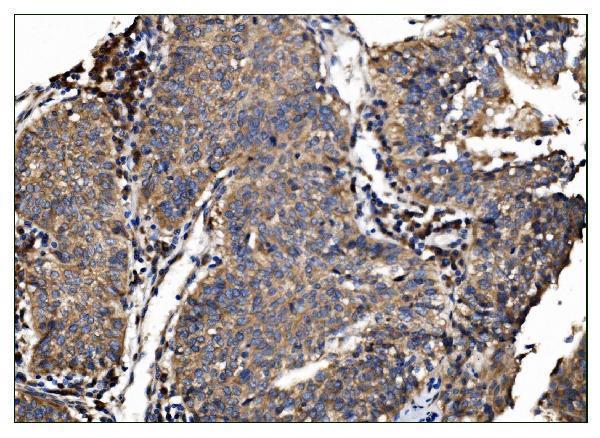
a02004 3 tbc1d4 primary antibodies ihc testing 4

Product Info Summary
| SKU: | A02004-3 |
|---|---|
| Size: | 100 μg/vial |
| Reactive Species: | Human |
| Host: | Rabbit |
| Application: | ELISA, Flow Cytometry, IF, IHC, ICC, WB |
Customers Who Bought This Also Bought
Product info
Product Name
Anti-AS160/TBC1D4 Antibody Picoband®
SKU/Catalog Number
A02004-3
Size
100 μg/vial
Form
Lyophilized
Description
Boster Bio Anti-AS160/TBC1D4 Antibody Picoband® catalog # A02004-3. Tested in ELISA, Flow Cytometry, IF, IHC, ICC, WB applications. This antibody reacts with Human. The brand Picoband indicates this is a premium antibody that guarantees superior quality, high affinity, and strong signals with minimal background in Western blot applications. Only our best-performing antibodies are designated as Picoband, ensuring unmatched performance.
Storage & Handling
Store at -20˚C for one year from date of receipt. After reconstitution, at 4˚C for one month. It can also be aliquotted and stored frozen at -20˚C for six months. Avoid repeated freeze-thaw cycles.
Cite This Product
Anti-AS160/TBC1D4 Antibody Picoband® (Boster Biological Technology, Pleasanton CA, USA, Catalog # A02004-3)
Host
Rabbit
Contents
Each vial contains 4mg Trehalose, 0.9mg NaCl, 0.2mg Na2HPO4.
Clonality
Polyclonal
Isotype
Rabbit IgG
Immunogen
E.coli-derived human TBC1D4 recombinant protein (Position: K1118-P1298).
Cross-reactivity
No cross-reactivity with other proteins.
Reactive Species
A02004-3 is reactive to TBC1D4 in Human
Observed Molecular Weight
160 kDa
Calculated molecular weight
146.6 kDa
Background of TBC1D4
AS160 (Akt substrate of 160 kDa), which was originally known asTBC1 domain family member 4 (TBC1D4),is a RabGTPase-activatingproteinthat in humans is encoded by theTBC1D4gene. This gene is a member of the Tre-2/BUB2/CDC16 domain family. This protein is thought to play an important role in glucose homeostasis by regulating the insulin-dependent trafficking of the glucose transporter 4 (GLUT4), important for removing glucose from the bloodstream into skeletal muscle and fat tissues. Reduced expression of this gene results in an increase in GLUT4 levels at the plasma membrane, suggesting that this protein is important in intracellular retention of GLUT4 under basal conditions. When exposed to insulin, this protein is phosphorylated, dissociates from GLUT4 vesicles, resulting in increased GLUT4 at the cell surface, and enhanced glucose transport. Phosphorylation of this protein by AKT is required for proper translocation of GLUT4 to the cell surface. Individuals homozygous for a mutation in this gene are at higher risk for type 2 diabetes and have higher levels of circulating glucose and insulin levels after glucose ingestion.
Antibody Validation
Boster validates all antibodies on WB, IHC, ICC, Immunofluorescence, and ELISA with known positive control and negative samples to ensure specificity and high affinity, including thorough antibody incubations.
Application & Images
Applications
A02004-3 is guaranteed for ELISA, Flow Cytometry, IF, IHC, ICC, WB Boster Guarantee
Recommend Dilution
| Application | Dilution | Species |
|---|---|---|
| Western blot | 0.25-0.5μg/ml | Human |
| Immunohistochemistry (Paraffin-embedded Section) | 2-5μg/ml | Human |
| Immunocytochemistry/Immunofluorescence | 5μg/ml | Human |
| Flow Cytometry (Fixed) | 1-3μg/1x106 cells | Human |
| ELISA | 0.1-0.5μg/ml | - |
Tested application
Suggested blocking solution with 5% non-fat milk or BSA; (*)Recommended protein loading: 20-40 µg per lane
Use TE buffer pH 9.0 for antigen retrieval; (*) citrate buffer pH 6.0 is an alternative.
Validation Images & Assay Conditions

Click image to see more details
Western blot analysis of AS160/TBC1D4 using anti-AS160/TBC1D4 antibody (A02004-3).
Electrophoresis was performed on a 5-20% SDS-PAGE gel at 70V (Stacking gel) / 90V (Resolving gel) for 2-3 hours. The sample well of each lane was loaded with 30 ug of sample under reducing conditions.
Lane 1: human Caco-2 whole cell lysates,
Lane 2: human Hela whole cell lysates,
Lane 3: human K562 whole cell lysates,
Lane 4: human HepG2 whole cell lysates.
After electrophoresis, proteins were transferred to a nitrocellulose membrane at 150 mA for 50-90 minutes. Blocked the membrane with 5% non-fat milk/TBS for 1.5 hour at RT. The membrane was incubated with rabbit anti-AS160/TBC1D4 antigen affinity purified polyclonal antibody (Catalog # A02004-3) at 0.5 μg/mL overnight at 4°C, then washed with TBS-0.1%Tween 3 times with 5 minutes each and probed with a goat anti-rabbit IgG-HRP secondary antibody at a dilution of 1:5000 for 1.5 hour at RT. The signal is developed using an Enhanced Chemiluminescent detection (ECL) kit (Catalog # EK1002) with Tanon 5200 system. A specific band was detected for AS160/TBC1D4 at approximately 160 kDa. The expected band size for AS160/TBC1D4 is at 160 kDa.
Click image to see more details
IHC analysis of AS160/TBC1D4 using anti-AS160/TBC1D4 antibody (A02004-3).
AS160/TBC1D4 was detected in a paraffin-embedded section of human gallbladder adenocarcinoma tissue. Heat mediated antigen retrieval was performed in EDTA buffer (pH 8.0, epitope retrieval solution). The tissue section was blocked with 10% goat serum. The tissue section was then incubated with 2 μg/ml rabbit anti-AS160/TBC1D4 Antibody (A02004-3) overnight at 4°C. Biotinylated goat anti-rabbit IgG was used as secondary antibody and incubated for 30 minutes at 37°C. The tissue section was developed using Strepavidin-Biotin-Complex (SABC) (Catalog # SA1022) with DAB as the chromogen.
Click image to see more details
IHC analysis of AS160/TBC1D4 using anti-AS160/TBC1D4 antibody (A02004-3).
AS160/TBC1D4 was detected in a paraffin-embedded section of human colonic adenocarcinoma tissue. Heat mediated antigen retrieval was performed in EDTA buffer (pH 8.0, epitope retrieval solution). The tissue section was blocked with 10% goat serum. The tissue section was then incubated with 2 μg/ml rabbit anti-AS160/TBC1D4 Antibody (A02004-3) overnight at 4°C. Biotinylated goat anti-rabbit IgG was used as secondary antibody and incubated for 30 minutes at 37°C. The tissue section was developed using Strepavidin-Biotin-Complex (SABC) (Catalog # SA1022) with DAB as the chromogen.
Click image to see more details
IHC analysis of AS160/TBC1D4 using anti-AS160/TBC1D4 antibody (A02004-3).
AS160/TBC1D4 was detected in a paraffin-embedded section of human lung cancer tissue. Heat mediated antigen retrieval was performed in EDTA buffer (pH 8.0, epitope retrieval solution). The tissue section was blocked with 10% goat serum. The tissue section was then incubated with 2 μg/ml rabbit anti-AS160/TBC1D4 Antibody (A02004-3) overnight at 4°C. Biotinylated goat anti-rabbit IgG was used as secondary antibody and incubated for 30 minutes at 37°C. The tissue section was developed using Strepavidin-Biotin-Complex (SABC) (Catalog # SA1022) with DAB as the chromogen.

Click image to see more details
IHC analysis of AS160/TBC1D4 using anti-AS160/TBC1D4 antibody (A02004-3).
AS160/TBC1D4 was detected in a paraffin-embedded section of human ovarian cancer tissue. Heat mediated antigen retrieval was performed in EDTA buffer (pH 8.0, epitope retrieval solution). The tissue section was blocked with 10% goat serum. The tissue section was then incubated with 2 μg/ml rabbit anti-AS160/TBC1D4 Antibody (A02004-3) overnight at 4°C. Biotinylated goat anti-rabbit IgG was used as secondary antibody and incubated for 30 minutes at 37°C. The tissue section was developed using Strepavidin-Biotin-Complex (SABC) (Catalog # SA1022) with DAB as the chromogen.

Click image to see more details
IHC analysis of AS160/TBC1D4 using anti-AS160/TBC1D4 antibody (A02004-3).
AS160/TBC1D4 was detected in a paraffin-embedded section of human renal clear cell carcinoma tissue. Heat mediated antigen retrieval was performed in EDTA buffer (pH 8.0, epitope retrieval solution). The tissue section was blocked with 10% goat serum. The tissue section was then incubated with 2 μg/ml rabbit anti-AS160/TBC1D4 Antibody (A02004-3) overnight at 4°C. Biotinylated goat anti-rabbit IgG was used as secondary antibody and incubated for 30 minutes at 37°C. The tissue section was developed using Strepavidin-Biotin-Complex (SABC) (Catalog # SA1022) with DAB as the chromogen.

Click image to see more details
IF analysis of AS160/TBC1D4 using anti-AS160/TBC1D4 antibody (A02004-3).
AS160/TBC1D4 was detected in an immunocytochemical section of Caco-2 cells. Enzyme antigen retrieval was performed using IHC enzyme antigen retrieval reagent (AR0022) for 15 mins. The cells were blocked with 10% goat serum. And then incubated with 5 μg/mL rabbit anti-AS160/TBC1D4 Antibody (A02004-3) overnight at 4°C. DyLight®488 Conjugated Goat Anti-Rabbit IgG (BA1127) was used as secondary antibody at 1:100 dilution and incubated for 30 minutes at 37°C. The section was counterstained with DAPI. Visualize using a fluorescence microscope and filter sets appropriate for the label used.

Click image to see more details
Flow Cytometry analysis of Hela cells using anti-AS160/TBC1D4 antibody (A02004-3).
Overlay histogram showing Hela cells stained with A02004-3 (Blue line). To facilitate intracellular staining, cells were fixed with 4% paraformaldehyde and permeabilized with permeabilization buffer. The cells were blocked with 10% normal goat serum. And then incubated with rabbit anti-AS160/TBC1D4 Antibody (A02004-3, 1 μg/1x106 cells) for 30 min at 20°C. DyLight®488 conjugated goat anti-rabbit IgG (BA1127, 5-10 μg/1x106 cells) was used as secondary antibody for 30 minutes at 20°C. Isotype control antibody (Green line) was rabbit IgG (1 μg/1x106) used under the same conditions. Unlabelled sample without incubation with primary antibody and secondary antibody (Red line) was used as a blank control.
Specific Publications For Anti-AS160/TBC1D4 Antibody Picoband® (A02004-3)
Loading publications
Recommended Resources
Here are featured tools and databases that you might find useful.
- Boster's Pathways Library
- Protein Databases
- Bioscience Research Protocol Resources
- Data Processing & Analysis Software
- Photo Editing Software
- Scientific Literature Resources
- Research Paper Management Tools
- Molecular Biology Software
- Primer Design Tools
- Bioinformatics Tools
- Phylogenetic Tree Analysis
Customer Reviews
Have you used Anti-AS160/TBC1D4 Antibody Picoband®?
Share your experimental results or join a short interview to earn up to $1,000 in product credits or other rewards.
0 Reviews For Anti-AS160/TBC1D4 Antibody Picoband®
Customer Q&As
Have a question?
Find answers in Q&As, reviews.
Can't find your answer?
Submit your question





